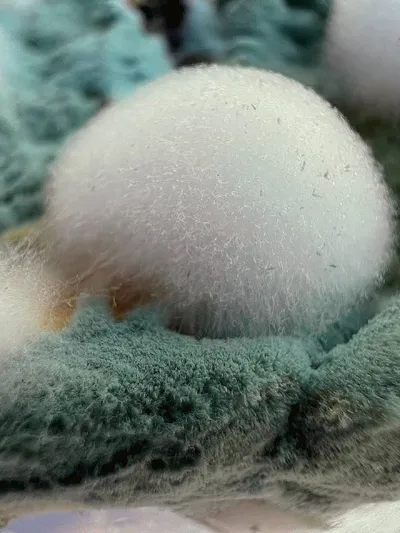

Страшная химия
Здоровье и ФитнесОльга Косникова. Число зверя, ой регистрация канала https://gosuslugi.ru/snet/67aa4eef962afd032d805465
Мониторьте этот канал — посты, тренды, конкуренты
Обзор канала
- Платформа Telegram
- Категория Здоровье и Фитнес
- Подписчики 31 800
- Температура Тёплый
- Постов/день 0.9
- Тип Публичный
Динамика подписчиков
Это ваш канал?
Подключите TeleGraphyx Traffic и получайте целевых подписчиков от 15₽. Интеграция с Яндекс.Директ, готовые лендинги, ежедневные отчёты.
Вовлечённость (ERR)
Анализ публикаций
30 днейТипы контента
Лучшее время (МСК)
Популярные посты
Читатели поделились красивейшими снимками плесени, выросшей на еде. Извинитесь, если зрелище неприятное. Мне оно кажется красивым 😏 Это к недавнему посту про плесени. Он прям стал хитовым в моим с

Кофеин: внутри и снаружи. Как на самом деле работают маски с лифтинг-эффектом? Тут должна быть шутка про миллениалов, которые состоят из кофе и печенек на 90%. Не буду томить: кофеин — реально рабочи

Как меня бомбит! Да как у вас женщины с гирсутизмом в мужчин с низким либидо превратились?! А две чашки в четыре? Что за пропаганда нескрепная 🤦♀️ Я может чего не понимаю?..
То, что курение табака в любом его виде может в принципе покоцать вам здоровье (в том числе и мужское, женское и крысиное), — неее, этот факт мы будем упорно игнорировать. Ведь если не курить ментол,

Мои первые духи: ностальгии пост. Ко мне вновь пришли дорогие Randewoo. И окунули в ностальгию. Я вспомнила свои первые духи, купленные в 14 лет на подаренные родными деньги. Это было 21 декабря 2003

Что заказать у Tasty Coffee? Подборка кофейно-чайных роскошеств. Ко мне приехала посылка от любимых ижевских обжарщиков Tasty Сoffee. Я люблю их много лет и даже в кофейнях Алматы регулярно нахожу им

Как угробить человека мёдом — без смс и регистрации 🤦♀️ В предыдущем посте я упомянула кейс Тодоренко. Это на самом деле леденящая кровь история про аллергию и лютое мракобесие. Есть такая ведущая

Продукты, опасные для мужчин: это вам никто не расскажет! Вы удивитесь, но существуют пищевые ограничения, связанные с биологическим полом. Например, вот что пишут в авторитетном издании Вконтакте бе

До бесстыдства неприличные вопросы вам! 1⃣ Чем опасна мята для мужчин? 2⃣ Чем опасны сигареты с ментолом для мужчин? 3⃣ Чем опасны стерилизованные консервы для мужчин? Девушки, к вам претензий нет
Сегодня не хочется банальностей, дорогие женщины-рептилоиды! Поэтому поделюсь шикарным постом про 8 марта от любимой гинеколога Динары Березиной ❤️ https://t.me/doctorberezina/1697 Ведь и правда. Т
Похожие каналы
Подобраны AI по тематике и контенту
Обзор канала
- Платформа Telegram
- Категория Здоровье и Фитнес
- Подписчики 31 800
- Температура Тёплый
- Постов/день 0.9
- Тип Публичный
Хотите контент как у лучших? AI сделает
AI изучит стиль топовых каналов в нише и создаст уникальные посты, обложки и стратегию для вашего канала. Полный автопилот — от идеи до публикации.
Подписывайтесь на наши каналы
Кейсы, лайфхаки и новости о продвижении в мессенджерах

